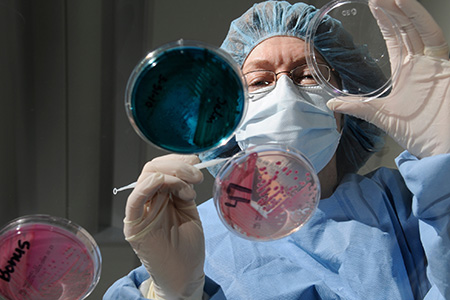

Top-Tier Research
Old Dominion University belongs to an elite group of institutions accounting for less than 5% of four-year research universities nationwide. Members of that group share the prestigious Research 1 (R1) Classification indicating “very high research activity.”


What It Means for Prospective Students & Faculty
- Increased value of an ODU degree.
- Greater potential for securing research dollars.
- Higher rate of upward mobility.

What R1 Means for the Region
A top-tier research institution can:
- Attract innovators and problem-solvers to tackle pressing community issues.
- Spur economic development.
- Encourage talent retention.
- Contribute to an ecosystem that supports entrepreneurship, commercialization and partnerships.
Research Powerhouse by the Sea
ODU’s R1 status and proximity to federal labs, the military, waterways and ocean makes it an appealing place to do impactful work. What's more, ODU is the most affordable R1 in Virginia.

Research Muscle
ODU is leading the way in:
- Coastal resilience
- Maritime
- Public health
- Cybersecurity
- Modeling and simulation
- Data science
- Bioelectrics
Research Relationships
ODU is a key academic partner for:
- Thomas Jefferson National Accelerator Facility (JLab)
- NASA Langley Research Center
- NASA Wallops Flight Facility
- National Oceanic and Atmospheric Administration
- Department of Defense
- Other federal agencies